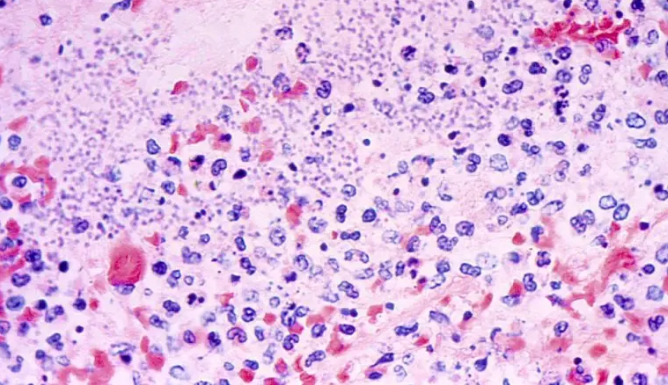

Health officials in Arizona have confirmed a rare and deadly case of pneumonic plague, marking a highly unusual instance of the disease in the United States. The unidentified patient, based in Coconino County, has died, local authorities announced Friday.
According to a statement from the Coconino County Health and Human Services Department, test results received this week confirmed the patient had contracted pneumonic plague, the most dangerous and least common form of the disease caused by the bacterium Yersinia pestis.
Pneumonic plague occurs when the bacteria infect the lungs, making it capable of spreading from person to person through airborne droplets — a feature that distinguishes it from other forms of plague such as bubonic and septicemic. While rare in the modern era, pneumonic plague is highly infectious and, without prompt treatment, can be fatal.
Health officials have not disclosed when the individual died or how the infection was contracted. An investigation is underway to determine the source and whether others may have been exposed.
Plague remains extremely rare in the United States, with only about seven cases reported annually, primarily in rural areas of western states such as Arizona, New Mexico, and Colorado, according to the U.S. Centers for Disease Control and Prevention (CDC). Globally, the disease remains endemic in a handful of countries, including Madagascar, the Democratic Republic of Congo, and Peru.
Although human-to-human transmission of pneumonic plague has not been recorded in the U.S. since 1924, the CDC notes that there have been sporadic cases tied to contact with infected animals — particularly cats, which are especially vulnerable after consuming infected rodents.
Experts stress that the general public faces minimal risk. However, those who work with animals or live in regions where the bacteria is known to circulate should take precautions.
Preventative measures include using insect repellent containing DEET to prevent flea bites, wearing gloves when handling animals, and keeping pets indoors in high-risk areas. The Cleveland Clinic advises vigilance around animals showing signs of illness, as plague can spread through close contact with infected pets.
There is currently no licensed plague vaccine available in the U.S., though research is ongoing. Antibiotics are effective if the disease is caught early, underscoring the importance of timely diagnosis and treatment.
Health officials urge residents to remain alert but not alarmed, noting that while the case is tragic, it remains an isolated incident.